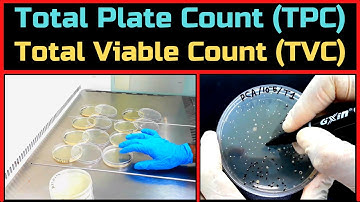
Total Plate Count (Total Aerobic Bacterial Count)_A Complete Procedure (BAM, Ch-3)

⬇ DOWNLOAD NOW
Kalau muncul iklan pop-up, tutup lalu klik tombol kembali
Download lagu Preparation of samples for microbial analysis secara gratis hanya untuk keperluan promosi. Dukung artis favorit kamu dengan membeli musik original di iTunes atau platform resmi lainnya.
 Sample Preparation for microbiological analysis using IntuGrow
Sample Preparation for microbiological analysis using IntuGrow
 Bacterial culture media |classification and types of bacterial media | enriched & differential media
Bacterial culture media |classification and types of bacterial media | enriched & differential media
 Microbiology of Milk
Microbiology of Milk
 Sample preparation
Sample preparation
 Detection of Escherichia coli (E. coli)_A Complete Procedure (ISO 9308-1 & ISO 16649)
Detection of Escherichia coli (E. coli)_A Complete Procedure (ISO 9308-1 & ISO 16649)
 Microbial Identification | Vitek 2 Compact | Vitek MS
Microbial Identification | Vitek 2 Compact | Vitek MS
Total Plate Count (Total Aerobic Bacterial Count)_A Complete Procedure (BAM, Ch-3)
Total Plate Count (Total Aerobic Bacterial Count)_A Complete Procedure (BAM, Ch-3)
 Pour Plate Technique for Colony Counting_A Complete Procedure (Microbiology)
Pour Plate Technique for Colony Counting_A Complete Procedure (Microbiology)